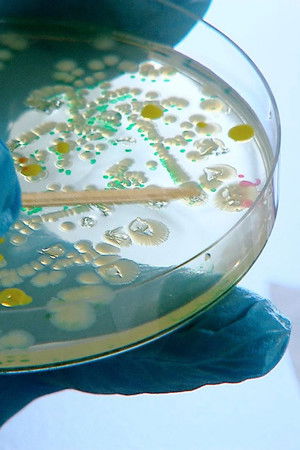

Movie Description
Recommendations
Saw: Rebirth
5.462
Friends Jokes
6.581
Telling Secrets
4.6
Lost
10
KARAKASA
6.4
Romance Proibido
9.5
Reverie
9
Facts
Original TitleKiller-Keime - Gefahr aus dem Tierstall
Status Released
Release Information
-
2014-01-09
Original LanguageUnknown
Production CompaniesARTE,NDR,Thurnfilm
Genres
- Documentary

![Eric Prydz - Tomorrowland 2020 [CELL.] Eric Prydz - Tomorrowland 2020 [CELL.]](https://image.tmdb.org/t/p/w300_and_h450_bestv2//1gEkvq6MmmhEl52GzA8QwS1R2ZY.jpg)
